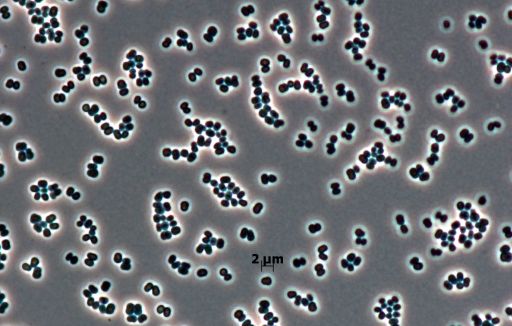

Topical Niacinamide in Daily Skincare: A 3-Week Real-World Cosmetic Study

Niacinamide, also known as nicotinamide, is a form of vitamin B3 (part of the vitamin B3 family which includes nicotinic acid and nicotinamide riboside) that is not endogenously synthesized by the body. Once absorbed, these forms are converted into nicotinamide…